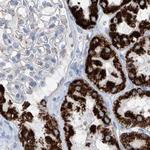
ALDH6A1 Antibody in Immunohistochemistry (Paraffin) (IHC (P))

Search
Invitrogen
ALDH6A1 Polyclonal Antibody
{{$productOrderCtrl.translations['antibody.pdp.commerceCard.promotion.promotions']}}
{{$productOrderCtrl.translations['antibody.pdp.commerceCard.promotion.viewpromo']}}
{{$productOrderCtrl.translations['antibody.pdp.commerceCard.promotion.promocode']}}: {{promo.promoCode}} {{promo.promoTitle}} {{promo.promoDescription}}. {{$productOrderCtrl.translations['antibody.pdp.commerceCard.promotion.learnmore']}}
图: 1 / 9
ALDH6A1 Antibody (PA5-83058) in IHC (P)

产品信息
PA5-83058
种属反应
宿主/亚型
分类
类型
抗原
偶联物
形式
浓度
规格
纯化类型
保存液
内含物
保存条件
运输条件
RRID
产品详细信息
Immunogen sequence: SCKRAFPAWA DTSVLSRQQV LLRYQQLIKE NLKEIAKLIT LEQGKTLADA EGDVFRGLQV VEHACSVTSL MMGETMPSIT
Highest antigen sequence indentity to the following orthologs: Mouse - 96%, Rat - 95%.
靶标信息
This protein belongs to the aldehyde dehydrogenases family of proteins. This enzyme plays a role in the valine and pyrimidine catabolic pathways. The product of this gene, a mitochondrial methylmalonate semialdehyde dehydrogenase, catalyzes the irreversible oxidative decarboxylation of malonate and methylmalonate semialdehydes to acetyl- and propionyl-CoA. Methylmalonate semialdehyde dehydrogenase deficiency is characterized by elevated beta-alanine, 3-hydroxypropionic acid, and both isomers of 3-amino and 3-hydroxyisobutyric acids in urine organic acids.
仅用于科研。不用于诊断过程。未经明确授权不得转售。
篇参考文献 (0)
生物信息学
蛋白别名: Aldehyde dehydrogenase family 6 member A1; aldehyde dehydrogenase family 6, subfamily A1; malonate-semialdehyde dehydrogenase; malonate-semialdehyde dehydrogenase (acetylating); Malonate-semialdehyde dehydrogenase [acylating]; methylmalonate semialdehyde dehydrogenase; methylmalonate-semialdehyde dehydrogenase [acylating], mitochondrial; Methylmalonate-semialdehyde/malonate-semialdehyde dehydrogenase [acylating], mitochondrial; MGC40271; mitochondrial acylating methylmalonate-semialdehyde dehydrogenase; MMSDH; testicular tissue protein Li 122; unnamed protein product
基因别名: 1110038I05Rik; AI314632; ALDH6A1; MMSADHA; MMSDH
UniProt ID: (Human) Q02252, (Rat) Q02253, (Mouse) Q9EQ20
Entrez Gene ID: (Human) 4329, (Rat) 81708, (Mouse) 104776




